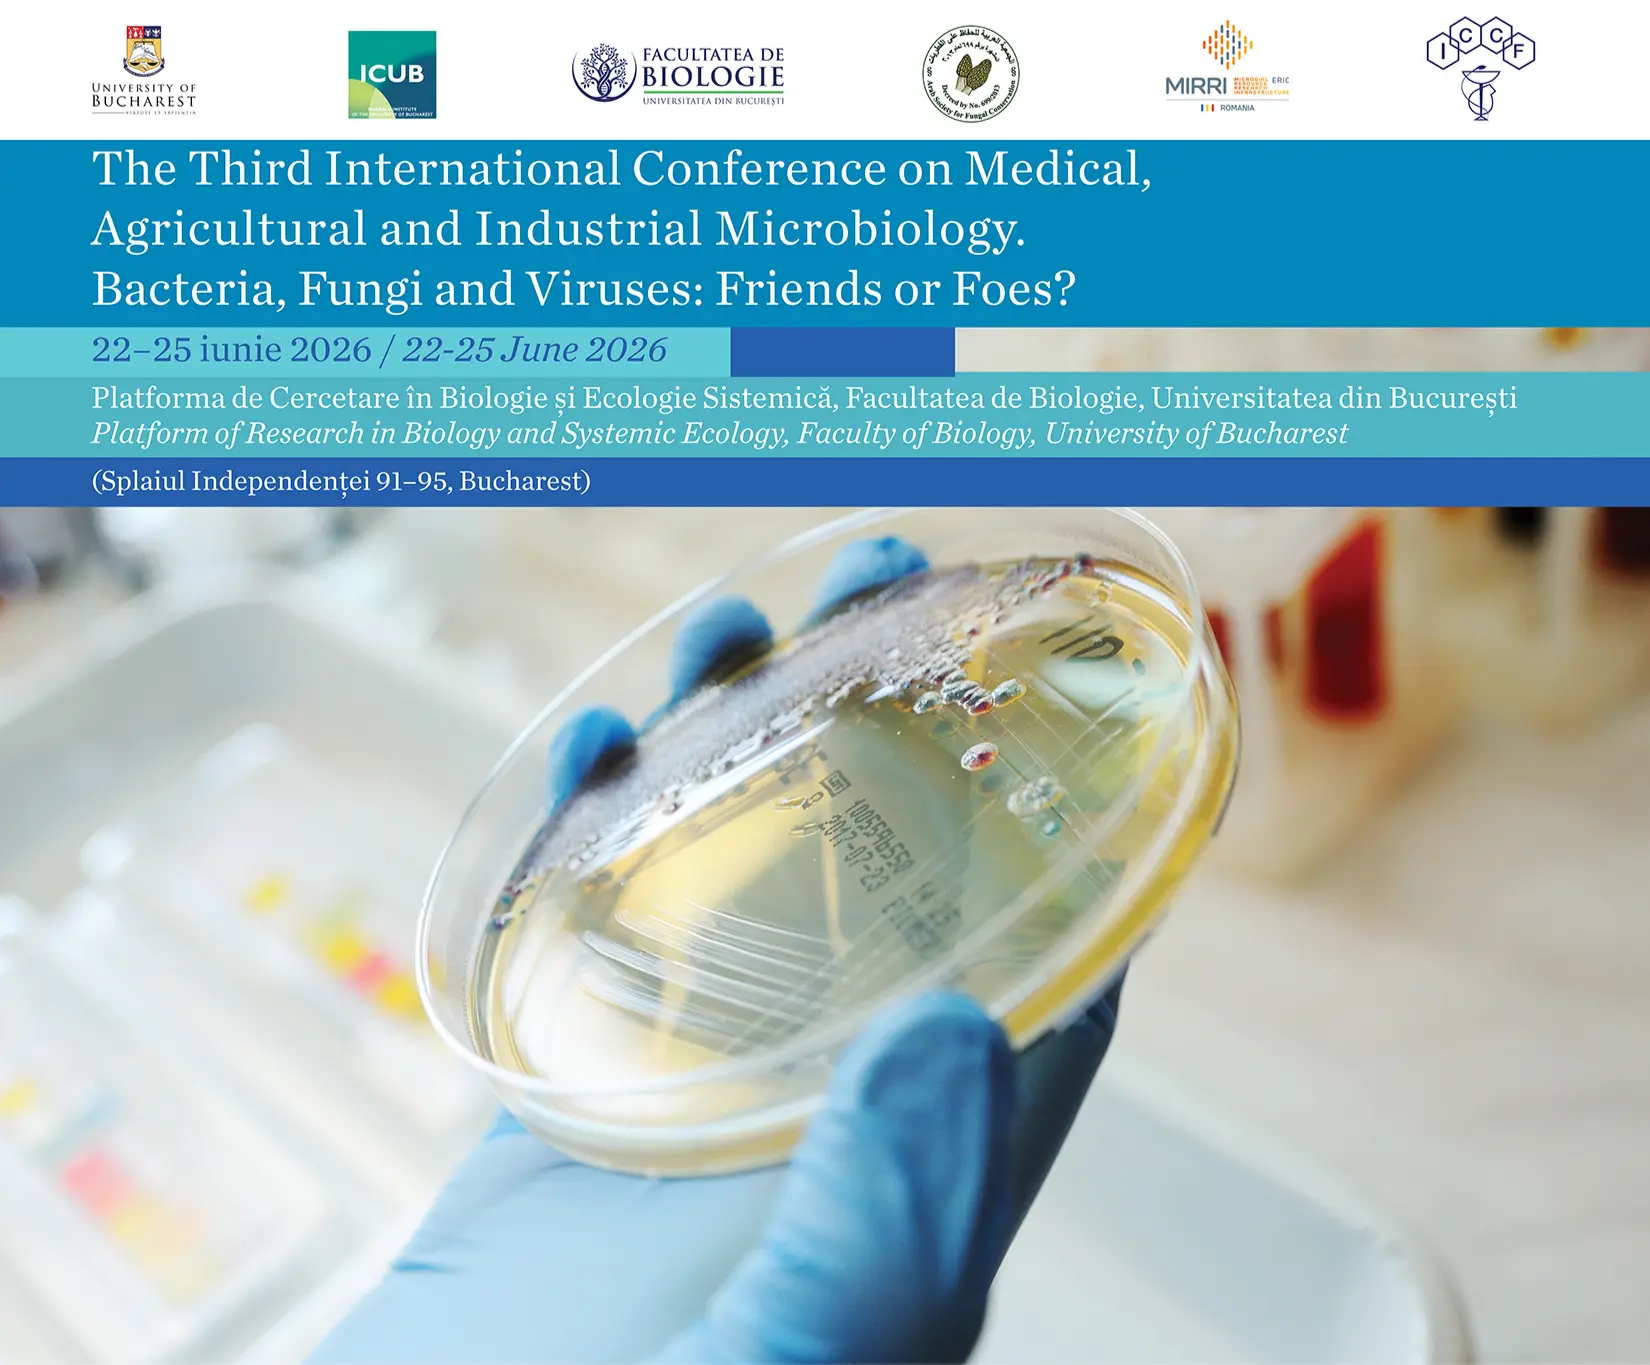

Muncitor calificat-fochist – 1 post
Direcția Generală Administrativă, Serviciul Întreținere și Reparații
📕 Studii: minimum 10 clase; autorizație de fochist – ISCIR; permis de conducere
✍️ Perioadă: nedeterminată
📅 Perioadă depunere dosare: 30.10.2025-12.11.2025
⌚ Normă: 8 ore/zi
Îngrijitor – 4 posturi
Direcția Generală Administrativă, Serviciul Curățenie
📕 Studii: minimum 10 clase
✍️ Perioadă: nedeterminată
📅 Perioadă depunere dosare: 30.10.2025-12.11.2025
⌚ Normă: 8 ore/zi
Îngrijitor – 4 posturi
Direcția Generală Administrativă, Serviciul Curățenie
📕 Studii: minimum 10 clase; vechime în muncă minimum un an
✍️ Perioadă: nedeterminată
📅 Perioadă depunere dosare: 25.08.2025-05.09.2025
⌚ Normă: 8 ore/zi
Portar – 1 post
Stațiunea Zoologică Sinaia
.
📕 Studii: minimum 10 clase; certificat sau adeverință din care să reiasă ca urmează cursuri de pază
✍️ Perioadă: nedeterminată
📅 Perioadă depunere dosare: 09.07.2025-22.07.2025
⌚ Normă: 8 ore/zi
Muncitor calificat-peisagist – 1 post
Grădina Botanică „D. Brandza”
.
📕 Studii: absolvent de liceu de specialitate (profil horticultură, agricultură sau resurse naturale și protecția mediului), SAU absolvent de liceu și al unui curs de calificare, dovedit cu certificate, în domeniul peisagist-floricultor, horticultură sau agricultură
✍️ Perioadă: nedeterminată
📅 Perioadă depunere dosare: 22.05.2025 – 04.06.2025
⌚ Normă: 8 ore/zi